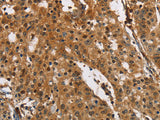
PTK6 Polyclonal Antibody Store at -20°C

PTK6 Polyclonal Antibody Store at -20°C
SKU: E-AB-11011-200
PTK6 Polyclonal Antibody Store at -20°C
| SKU # | E-AB-11011 |
| Reactivity | Human, Mouse |
| Host | Rabbit |
| Applications | IHC |
Product Details
| Isotype | IgG |
| Host | Rabbit |
| Reactivity | Human, Mouse |
| Applications | IHC |
| Clonality | Polyclonal |
| Immunogen | Recombinant protein of human PTK6 |
| Abbre | PTK6 |
| Synonyms | Breast tumor kinase, Breast tumour kinase, PTK6, Protein tyrosine kinase 6, Protein-tyrosine kinase 6, Ptk6, Tyrosine protein kinase BRK, Tyrosine-protein kinase BRK |
| Swissprot | |
| Cellular Localization | Cytoplasm. Nucleus. Colocalizes with KHDRBS1, KHDRBS2 or KHDRBS3, within the nucleus. In secretory epithelial cells from prostate adenocarcinoma, nuclear localization is higher in low-grade and lower in high-grade regions of the tumors. |
| Concentration | 0.3 mg/mL |
| Buffer | Phosphate buffered solution, pH 7.4, containing 0.05% stabilizer and 50% glycerol. |
| Purification Method | Affinity purification |
| Research Areas | Cancer, Signal Transduction |
| Conjugation | Unconjugated |
| Storage | Store at -20°C Valid for 12 months. Avoid freeze / thaw cycles. |
| Shipping | The product is shipped with ice pack,upon receipt,store it immediately at the temperature recommended. |
Related Reagents
| Applications | Recommended Dilution |
| IHC | 1:50-1:200 |
Background
The protein encoded by this gene is a cytoplasmic nonreceptor protein kinase whicHuman, Mouseay function as an intracellular signal transducer in epithelial tissues. Overexpression of this gene in mammary epithelial cells leads to sensitization of the cells to epidermal growth factor and results in a partially transformed phenotype. Expression of this gene has been detected at low levels in some breast tumors but not in normal breast tissue. The encoded protein has been shown to undergo autophosphorylation. Alternative splicing results in multiple transcript variants.